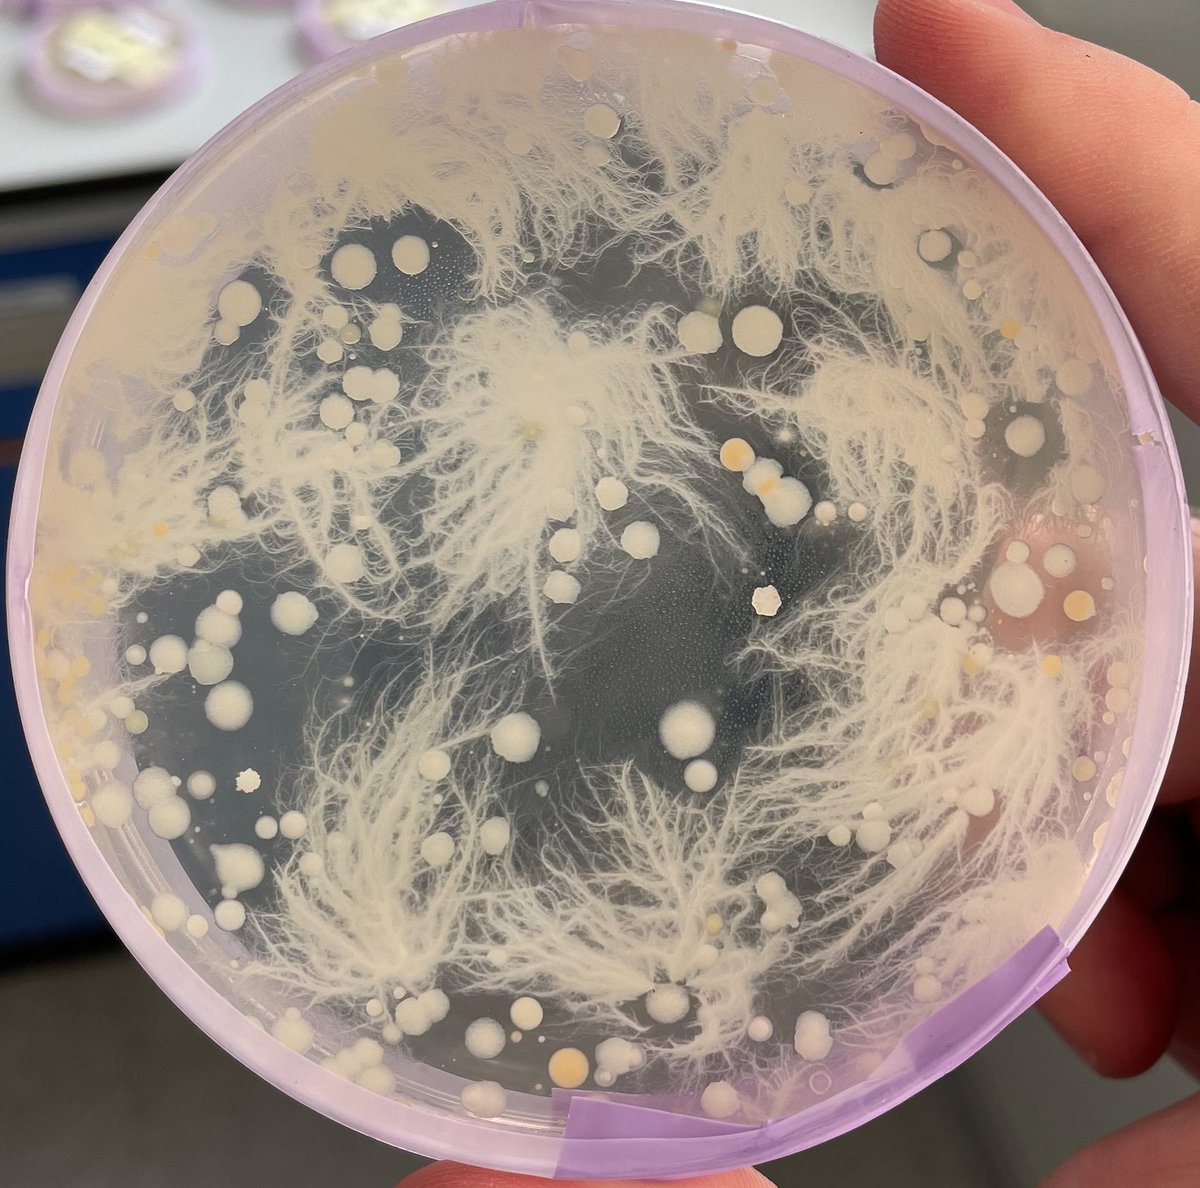
Micro_Mad's tweet image. It was great to meet so many people at #CoCoMAD on Saturday!
The plates have been growing in our lab @IMIBirmingham, and they&apos;re looking beautiful! 
Here are a couple that caught our eye - check back on Friday to find yours!
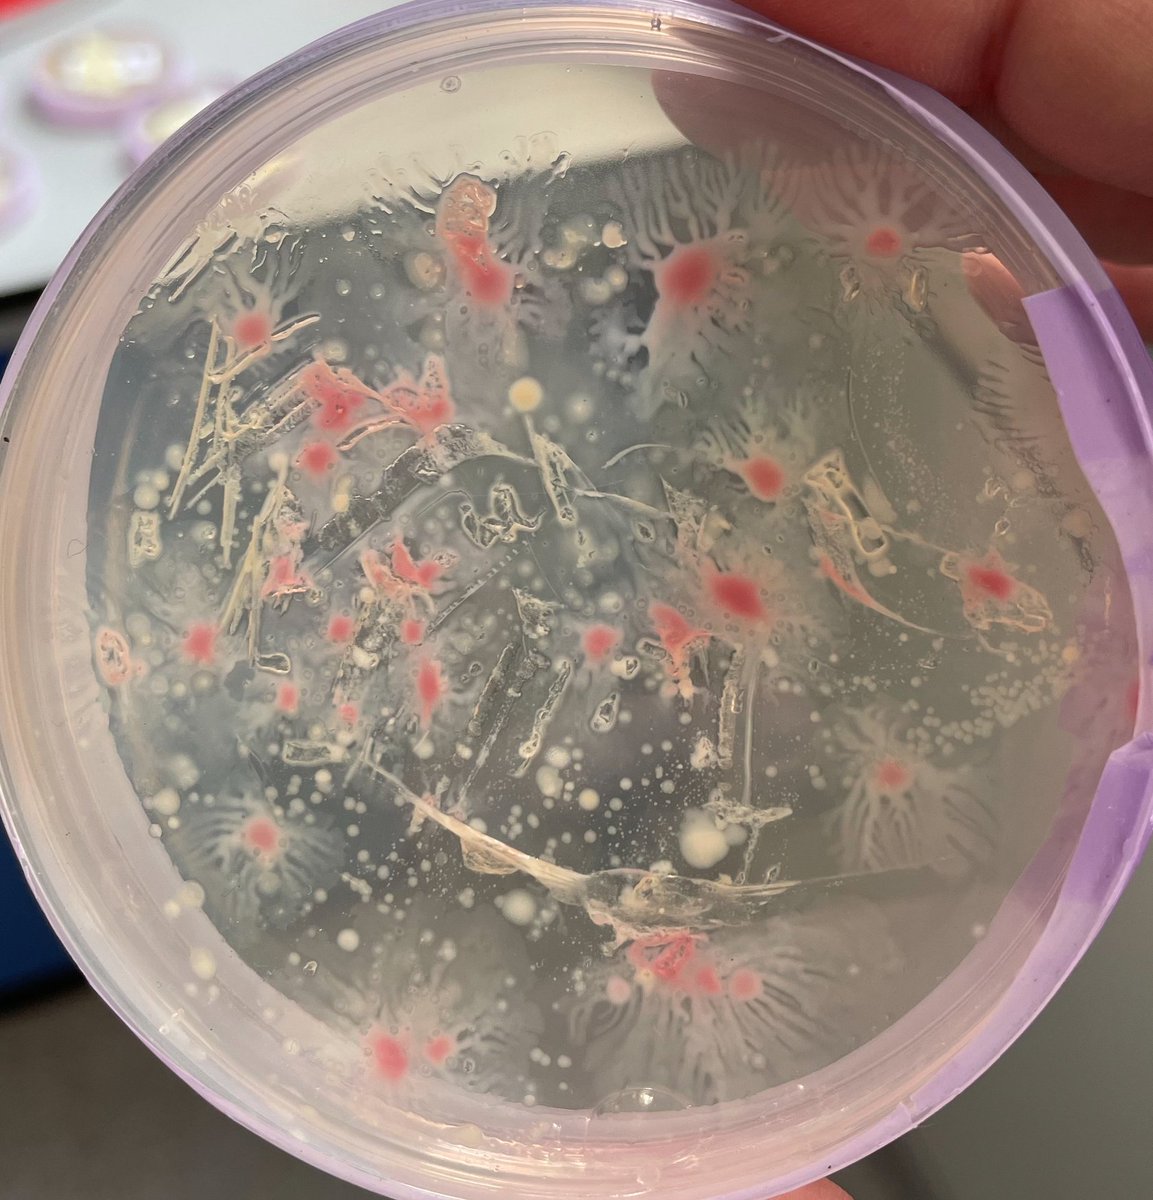
Micro_Mad's tweet image. It was great to meet so many people at #CoCoMAD on Saturday!
The plates have been growing in our lab @IMIBirmingham, and they&apos;re looking beautiful! 
Here are a couple that caught our eye - check back on Friday to find yours!

Emma Simpson
@ekd_simpson
PhD with Integrated Studies in Formulation Engineering: Targeting staphylococcal colonisation and virulence at the Uni of Birmingham. Sponsored by L'ORÉAL.
You might like
New career in 2024? Come and join us @WarwickLifeSci and @uniofwarwick where big ideas have big impact! We're hiring 3 x new Assist/Assoc Profs in: - Human-Microbe Interactions - Ecology and Evolution - Cardiorespiratory Physiology Closing date 3rd Jan bit.ly/slsacademicvac…

Introducing the ContamCalendar 2024 📆🦠🧫🍄 on sale tomorrow! Loved putting this together, can't wait for you guys to get your hands on this 💥 Retweet, like, and follow @ContamClub for your chance to win one 💥

Won a #Merckpins today! It is sitting at my desk next to the pigs! Can't wait to grow my collection of pins .... and pigs! @SigmaAldrich @merckgroup

It was great to meet so many people at #CoCoMAD on Saturday! The plates have been growing in our lab @IMIBirmingham, and they're looking beautiful! Here are a couple that caught our eye - check back on Friday to find yours!

Sharon Peacock from @Cambridge_Uni closes the day at #Microbio23 with her Marjory Stephenson Prize Lecture: Sequencing Microbes for Better Human Health in Hall 1. Find out more about Sharon and her research in this interview: microb.io/41xJOZY 👈

Excellent talk by Sharon Peacock @Cambridge_Uni. Her Marjory Stephenson Prize Lecture: Sequencing Microbes for Better Human Health was amazing and it was an absolute pleasure to interview you for @MicrobioSoc. Find the full details here! microb.io/41xJOZY 👈
Really enjoyed presenting my poster today #Microbio23 - my poster (P245) will be up until tomorrow if you want to read about staph epi and atopic dermatitis! #atopicdermatitis

The stairs outside Mr Baldwin's office have been #yarnbombed for a GCSE Art project. We love the new colourful stairs

United States Trends
- 1. Thanksgiving 406K posts
- 2. National Guard 29.1K posts
- 3. Golesh 2,862 posts
- 4. Bayern 148K posts
- 5. Camp Haven 7,570 posts
- 6. Arsenal 273K posts
- 7. Denzel 3,826 posts
- 8. Fani Willis 20.5K posts
- 9. Pizza 47.7K posts
- 10. #WipersDayGiveaway N/A
- 11. Wine 39.7K posts
- 12. Trumplican 3,675 posts
- 13. NextNRG Inc 1,454 posts
- 14. Hong Kong 91.2K posts
- 15. Khabib 7,913 posts
- 16. Olympiacos 13.8K posts
- 17. Tom Hardy 1,998 posts
- 18. DC Police 4,975 posts
- 19. Cori 1,955 posts
- 20. Neuer 5,125 posts
Something went wrong.
Something went wrong.







































































